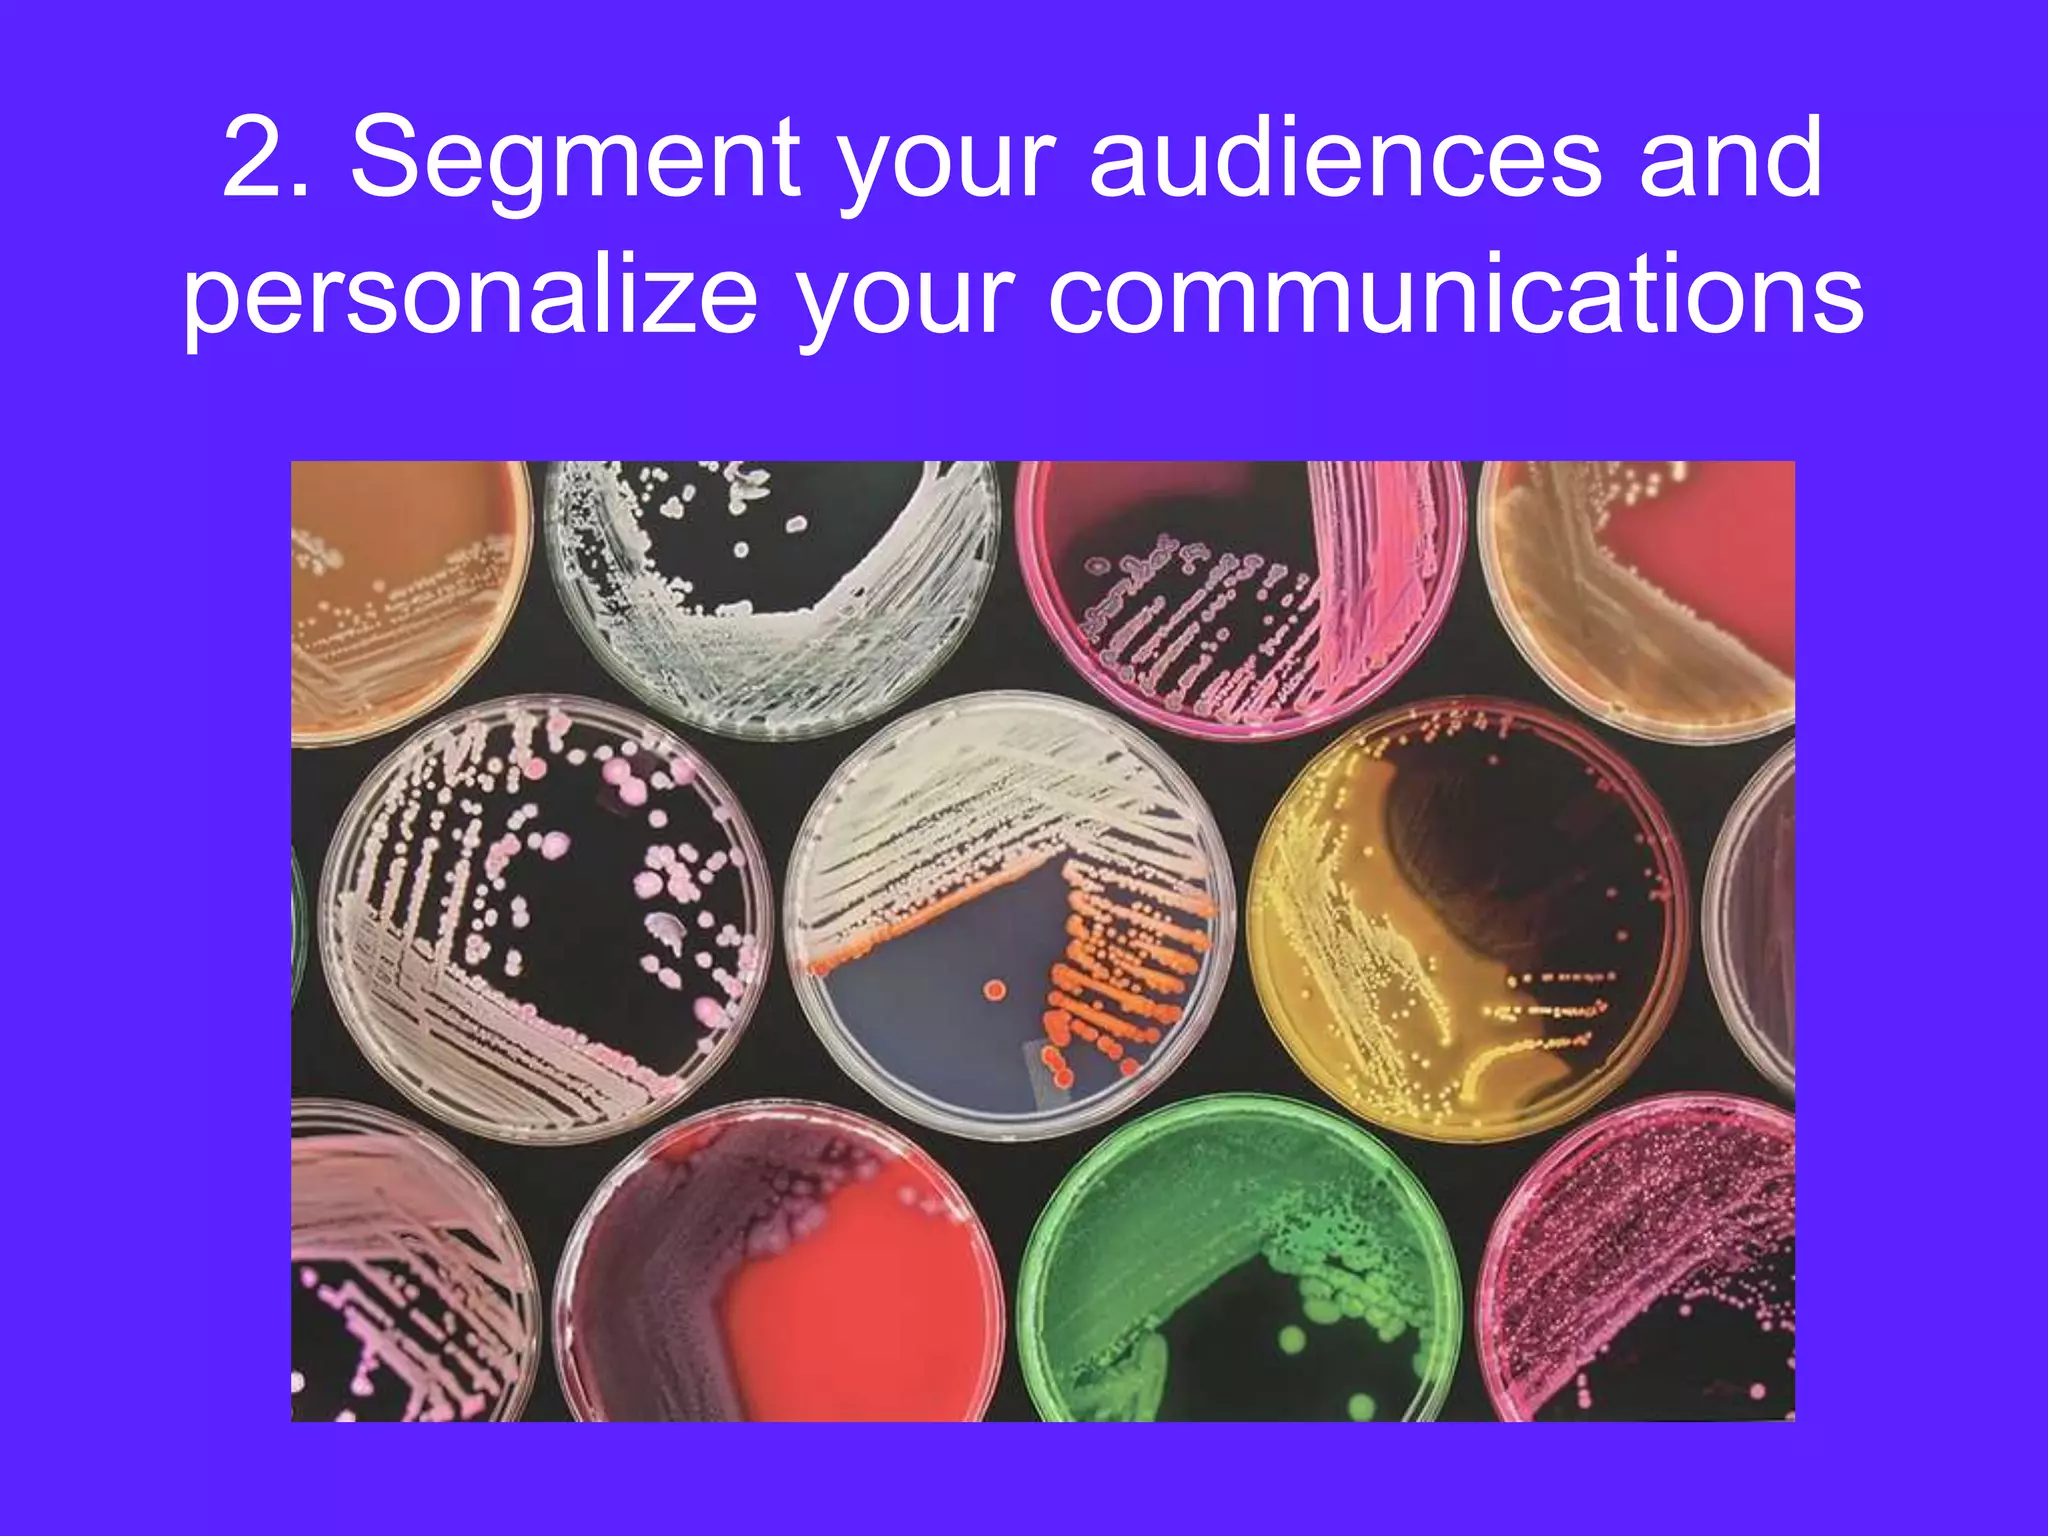
2. Segment your audiences and
personalize your communications

This document discusses how to boost conversions and generate more business without spending more on ads. It provides an overview of SalesRev, which offers conversion optimization and marketing automation services. The presentation then outlines four key steps: 1) optimize ads, 2) optimize the website for conversions, 3) nurture leads with personalization and automation, and 4) close the deal. Various tactics are described under each step, such as ad-level ROI tracking, remarketing, personalized email drips, and syncing with a CRM. Case studies show how SalesRev helped companies attract, convert, and close more leads. Overall lessons emphasize identifying pain points, segmenting audiences, understanding capabilities, and being transparent.